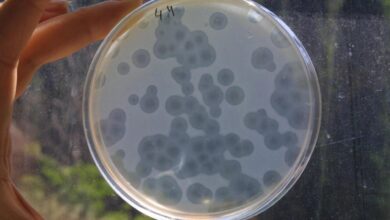

آخر الأخبارأخبار محلية
مشاهد جديدة من بلدة أيطو… كم بلغ عدد الشهداء حتّى الآن؟ (فيديو)

أفادت مندوبة “لبنان 24” عن إستشهاد 3 أشخاص في بلدة أيطو على طريق زغرتا، بعدما استهدف العدوّ الإسرائيليّ شقة هناك.
وعمل الجيش على مساعدة فرق الإنقاذ بنقل الجرحى إلى مستشفيات الشمال.
مصدر الخبر
للمزيد Facebook